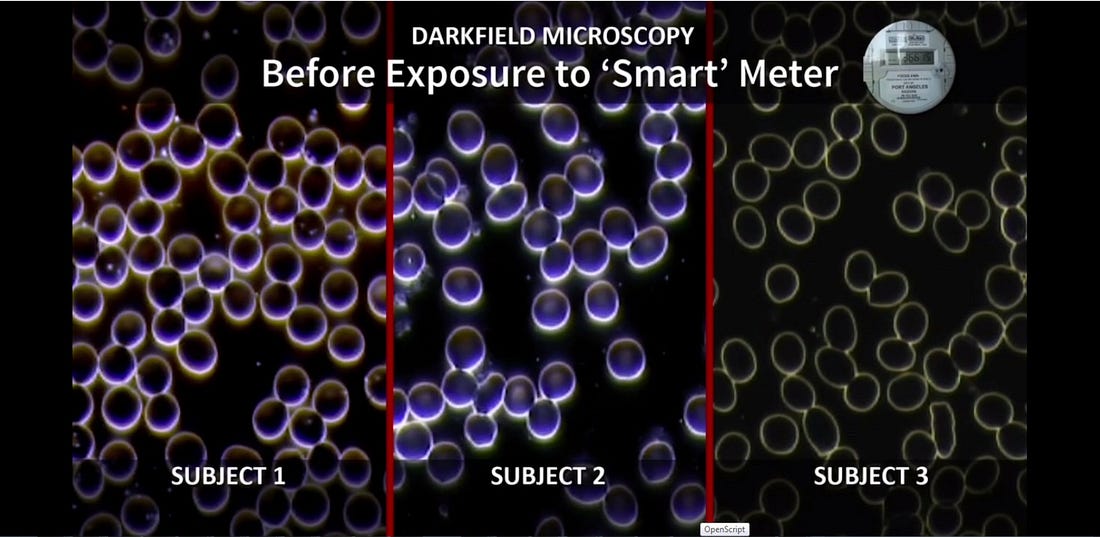

Wireless Radiation & Frequencies Cause Blood Clotting Within Two Minutes of Exposure
I am not making this up.See images below and notice how the blood starts to look like cooked meat and the cells also become deformed.MICROWAVES COOK THINGS!!YOUR DEVICES ARE LITERALLY COOKING YOUR INSIDES AND THE INSIDES OF YOUR CHILDREN AND PETS.PLEASE WAKE UP.Photo credits to Magda Havas, Lena Pu and Josh del Sol, in that order.PLEASE NOTE:People blame the “clot shot” for the horrid blood clots we are now seeing in huge numbers of people (and probably pets as well). But the truth is, it is the self-assembling, wireless operating system that people have been injected with that is causing their blood to create deadly clots. The jabbed people have become walking wireless transmitters and receivers. And those alien “calamari” clots we now see in so many people are caused by a combination of the ingredients in the jab (especially hydrogels and graphene) combined with the wireless frequencies and radiation that cause it all to coagulate and come together FOR THE PURPOSE OF KILLING PEOPLE.The wireless frequencies are the key to making it all happen folks.The entire wireless grid must be immediately shut down if we hope to stop the wave of death now underway.
You’re currently a free subscriber to BirthofaNewEarth Substack. For the full experience, upgrade your subscription. |